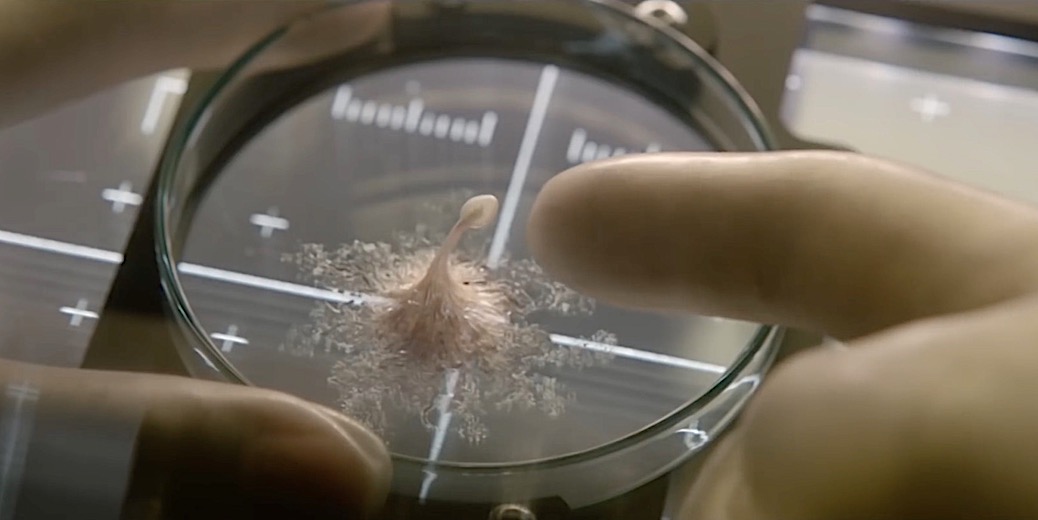

Muita gente tenta, ninguém consegue: Alien continua a ser o auge da evolução
ATENÇÃO: Todas as informações deste primeiro parágrafo estão no trailer. Mas, se você não quer saber de nada, talvez as considere spoiler.
Olhe que linda esta célula vinda de Marte: tem núcleo, como as daqui, e uns cílios tão longos e delicados… Pena que está dormente. Vamos tentar despertá-la, ora. É só subir a temperatura, dar uma ajustada na atmosfera, fornecer uns nutrientes. Pronto, ela já está se mexendo. E se multiplicando. E que coisa, as células não se diferenciam; são todas idênticas, mas cooperam. E o organismo cresce tão rápido! E parece tão faminto, e tão inteligente. Mas veja bem, nada de deixá-lo escapar da quarentena. Ops! Já era.

Em Vida, os seis astronautas/pesquisadores das Estação Espacial Internacional (ISS, em inglês) cometem o erro clássico da ficção científica: vão mexer com uma forma de vida alienígena que, é evidente, foge ao seu controle para ocupar seu lugar de direito na cadeia alimentar – acima dos bípedes curiosos que foram tirá-la do seu isolamento ou hibernação. As duas hipóteses são perfeitamente razoáveis: é quase certo que a curiosidade humana venceria a prudência diante de uma descoberta como essa, e é bem possível que uma forma de vida alienígena constituísse uma ameaça. O difícil é dar a essa história um ar de novidade. Desde que Ridley Scott lançou Alien – O Oitavo Passageiro, em 1979, o trabalho dos roteiristas e diretores de ficção científica virou uma pedreira. A ferocidade de uma vida estranha, o confinamento junto com o perigo em um lugar do qual não se pode escapar, a impossibilidade de eliminar a ameaça – Scott matou a pau em tudo, e fez uma das oito ou dez ficções científicas definitivas da história do cinema. Alien é um predador alfa, e quem entra no território da vida alienígena virtualmente não tem como escapar dele (a não ser que pegue uma rota totalmente diferente, como fez A Chegada). Ele sufoca, engole ou devora todos os pretendentes ao seu posto. Se você nunca viu, está mais do que na hora de ver – e aí a gente avisa quando aparecer outra coisa que se compare.

O diretor sueco Daniel Espinosa, de Protegendo o Inimigo, “cola” também do Gravidade de Alfonso Cuarón, mas tenta fazer com que o empréstimo trabalhe a seu favor, brincando com as expectativas que esses filmes criaram na plateia. O sucesso dessa tática é relativo, já que nunca é uma boa ideia fazer a plateia lembrar constantemente de filmes melhores do que o seu. Não ajuda, também, que os personagens sejam os de sempre – o mecânico caubói, a médica conscienciosa, o pai que ainda não conheceu o bebê recém-nascido. O elenco, em contrapartida, é ótimo: Ryan Reynolds, Rebecca Ferguson, o excelente Hiroyuki Sanada e os simpáticos Ariyon Bakare e Olga Dihovichanaya, com destaque para Jake Gyllenhaal como o astronauta que está batendo recordes de permanência na ISS porque não suporta a ideia de voltar à Terra. Ainda que Vida nunca consiga ser mais do que a soma das suas partes, porém, ele tem suas compensações. A maior delas é o final – aí, sim, Espinosa consegue combinar com alguma inovação o DNA de Alien e o de Gravidade, e ainda deixar um gancho descarado (mas bacana) para uma eventual continuação. A qual tem poucas chances de acontecer: o público sacou na hora o sabor de prato requentado, e não está fazendo muita questão de pagar para provar dele.
Trailer
VIDA
(Life)
Estados Unidos, 2017
Direção: Daniel Espinosa
Com Jake Gyllenhaal, Ryan Reynolds, Rebecca Ferguson, Hiroyuki Sanada, Ariyon Bakare, Olga Dihovichanaya
Distribuição: Sony Pictures